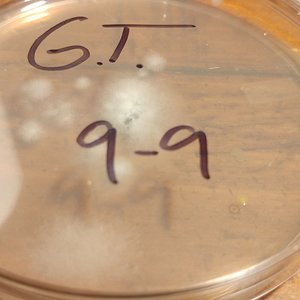
GT 9-16
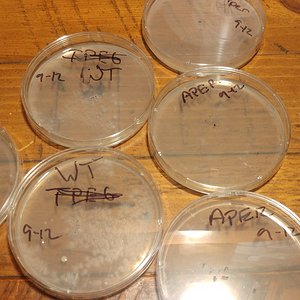
9-16
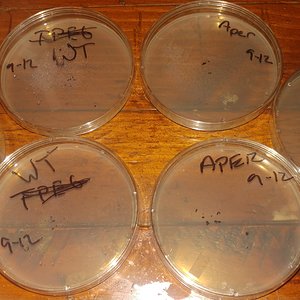
GT, WT, and APER

-
We are officially moved over to Discourse.
Autoflower Discourse"
You will have to create a new login for the new site!
This current Xenforo-based forum will be preserved as a read-only archive going forward with efforts to better categorize and tag original and canonical content.
The URL autoflower.org will soon point to the new Discourse site; so we'll be back to business in a few days!
Send Son of Hobbes a private message if you have any questions!